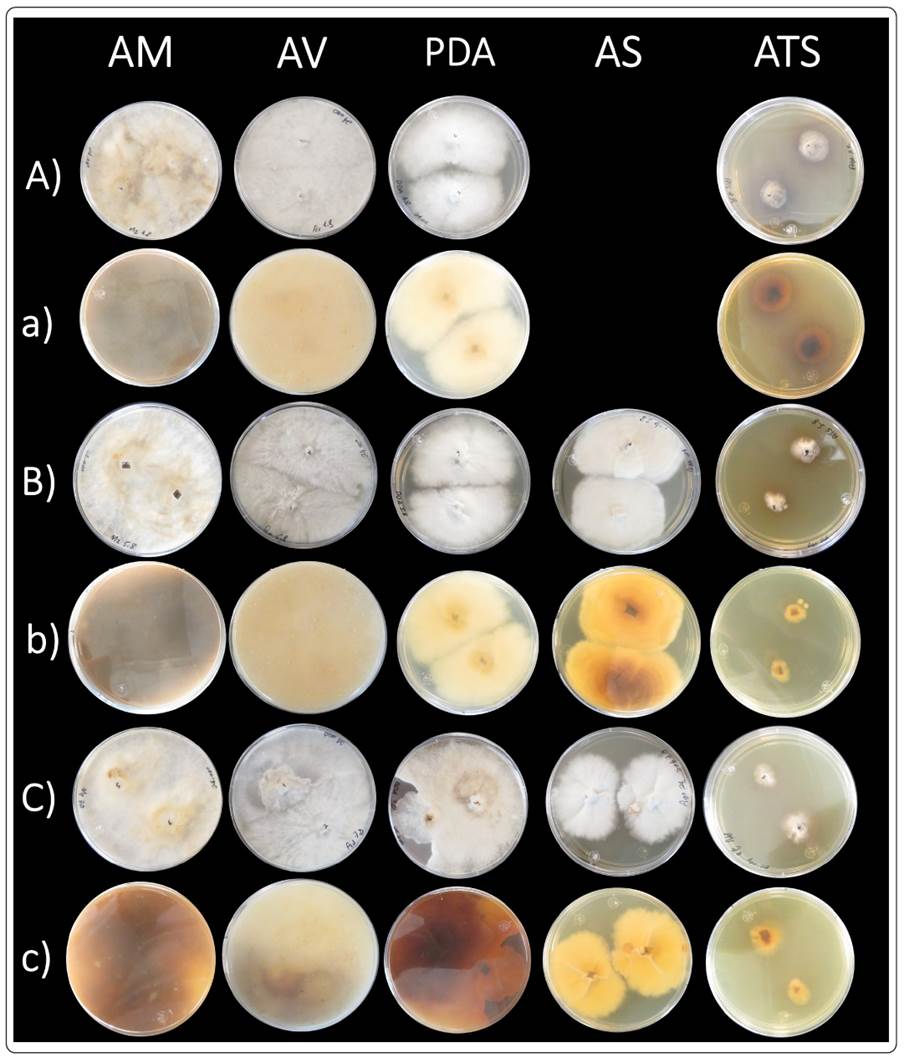

INTRODUCCIÓN
Podaxis pistillaris (L. Pers.) Morse agg. es un hongo que pertenece a la familia Agaricaceae (Basidiomycota) con características gasteroides (Conlon et al., 2019). Se distribuye principalmente, en suelos arenosos de las regiones áridas o semiáridas del mundo (Conlon, De Beer, Henrik, Aanen & Poulsen, 2016). Los carpóforos aparecen posterior a la temporada de lluvias y suelen crecer solitarios o en grupos, y ocasionalmente en simbiosis con termitas en los desiertos de América, África, Australia y Asia (El-Fallal, El-Sayed & El-Gharabawy, 2019; Buys et al., 2018).
Los carpóforos de P. pistillaris se recolectan en los hábitats mencionados para consumo alimenticio y uso medicinal (Al-Fatimi, Jülich, Jansen & Lindequist, 2006), además de presentar una importante actividad enzimática fibrolítica (Rascón-Chu et al., 2019). En India, Arabia Saudita y Afganistán se consumen frescos (principalmente en estadio juvenil) o secos (Feleke & Doshi, 2017; Mridu & Atri, 2015). En Yemen y Sudáfrica se reporta su uso en la medicina tradicional para el tratamiento de enfermedades de la piel y quemaduras solares, y en China se ha usado para aliviar la inflamación (Al-Fatimi et al., 2006; Al-Fatimi, 2001). Por otra parte, sus esporas se han utilizado con fines estéticos por algunas tribus australianas, ya sea para oscurecer el vello facial o para pintar el cuerpo, así como repelente para los insectos (Priest & Lenz, 1999). Se sabe que los carpóforos son ricos en proteínas, en carbohidratos, en minerales y en lípidos (Mridu & Atri, 2015; Muhsin, Abass & Al-Habeeb, 2012). Se ha detectado también que los extractos etanólicos y metanólicos de P. pistillaris en la fase micelial y la carpoforal tienen propiedades antimicrobianas sobre las bacterias patógenas de los humanos y las vegetales, así como en los hongos fitopatógenos (Feleke & Doshi, 2017; Al-Fatimi, 2006; Panwar & Purohit, 2002).
En México, se ha reportado la presencia de P. pistillaris en áreas abiertas, sobre el suelo arenoso o el arcilloso de zonas áridas y tropicales, principalmente en los estados de Baja California, Chihuahua, Sonora, Coahuila, Durango, Nuevo León, Tamaulipas, Oaxaca y en la Ciudad de México (Medina-Ortiz et al., 2017; Moreno, Lizárraga, Esqueda & Coronado, 2010). Su consumo solamente ha sido registrado en la región de la Cañada en Oaxaca por Medina-Ortiz, Herrera, Vásquez-Dávila, Raja & Figueroa (2017), quienes mencionan que es ampliamente recolectado, consumido e inclusive vendido durante los periodos de lluvia. Sin embargo, no se han realizado estudios de la composición proximal o potencial de la inhibición microbiana de P. pistillaris en el norte de México. El objetivo del presente estudio es determinar la composición proximal y actividad antimicrobiana de P. pistillaris recolectado en el norte del desierto Chihuahuense, así como el conocer qué medios de cultivo in vitro son los más eficaces para su propagación en el laboratorio.
Materiales y métodos
Recolecta del carpóforo
Las muestras se obtuvieron en distintos puntos de la zona perimetral Cuatro Siglos, en Ciudad Juárez, Chihuahua, entre las coordenadas (31.752349, -106.426393 y 31.660237, -106.332765), principalmente de zonas con suelo arenoso y/o pedregoso, durante los meses de agosto a septiembre del 2019. Los carpóforos fueron retirados del sustrato con ayuda de una navaja estéril, y guardados en bolsas de papel etiquetadas para su traslado al laboratorio de Biodiversidad de la Universidad Autónoma de Ciudad Juárez (UACJ), donde se identificaron taxonómicamente y se refrigeraron a 4 °C hasta su posterior uso.
Identificación taxonómica
Los carpóforos se identificaron con base en su apariencia morfológica (forma del carpóforo, color, textura del píleo y estípite, presencia o ausencia de cualquier estructura o característica del cuerpo fructífero como escamas, verrugas, pelos, etc.). Las estructuras microscópicas se estudiaron con preparaciones temporales en KOH al 5%, se observaron y midieron las estructuras importantes para su identificación, como son las esporas, basidios, e hifas (Largent, 1986; Largent, Johnson, Watling, 1977). Para las mediciones se usó un microscopio compuesto binocular marca Leica modelo DME, que tiene incluido un micrómetro ocular graduado y un portaobjetos también graduado para su calibración. Los resultados se compararon con las descripciones de las especies de los hongos que se encuentran en la literatura existente (El Fallal et al., 2019; Medina-Ortiz et al., 2017; Muhsin et al., 2012).
Análisis proximal
Se determinó la composición proximal del carpóforo completo, el estípite y el píleo, utilizando 100 g de carpóforo/parte del carpóforo molido y un homogeneizado de todas las muestras recolectadas en la temporada de lluvia durante el año 2019. El contenido de la humedad y la materia seca se obtuvieron a través del método estandarizado de la AOAC (2000) con el secado en la estufa (926.08); las cenizas con el método de calcinación en mufla (935.42) (AOAC, 2000); las proteínas a través del método Kjeldhal (920.123-1920), usando un factor de conversión de 4.38 (AOAC, 2000); el contenido total de grasa se cuantificó con el método de Soxhlet (AOAC, 2000); por último, los carbohidratos totales se determinaron por la diferencia de la composición total del producto (FAO, 2002). El contenido de sodio se estimó por estequiometría de NaCl, con el método de Volhard (935.43) (AOAC, 2000). El cálculo de energía (kcal/100 g) en las diferentes partes del hongo se realizó con el sistema de factor general de Atwater (DFI, 2015). Finalmente, el contenido de fibra cruda (FC) se obtuvo con el método Labconco (AOAC, 1990).
Tratamiento de las muestras para el análisis de la actividad antimicrobiana
Los carpóforos se limpiaron, se congelaron a -80 °C, y se sometieron a un proceso de liofilización en condiciones de vacío para deshidratarlos. En seguida, las muestras se pulverizaron en un procesador de alimentos, para ser almacenadas en bolsas de plástico a -20 °C hasta su uso.
Preparación del extracto
El extracto utilizado para determinar la capacidad antimicrobiana se preparó usando 10 g del carpóforo completo pulverizado. En primer lugar, se dejó en reposo con 200 mL de metanol durante 24 h a temperatura ambiente; transcurrido el tiempo, se sometió a sonicación en un baño ultrasónico por 30 min (Bala, Aitken, Fechner, Cusack & Steadman, 2011). Posteriormente, la mezcla se centrifugó (IEC clinical centrifuge, mod. 120) durante 10 min para su sedimentación a una velocidad de 3 000 rpm, se decantó el sobrenadante, y para concentrar el extracto se evaporó el solvente hasta sequedad bajo presión reducida en un rotavapor. Finalmente, se redisolvió en metanol a una concentración de 50 mg/mL y se esterilizó con un filtro de membrana de 0.22 µm (Giri, Biswas, Pradhan, Mandal & Acharya, 2012).
Microorganismos y condiciones de crecimiento
Los microorganismos seleccionados para las pruebas de actividad antimicrobiana fueron Streptococcus agalactiae y Candida albicans. Se trata de una microbiota oportunista, causante de infecciones en personas inmunocomprometidas, en gestantes, en recién nacidos y en los adultos mayores; se ha registrado también su resistencia a algunos antibióticos como la penicilina, los azoles y las equinocandidas (Shokohi et al., 2018; Le Doare & Heath, 2013). Ambas muestras fueron donadas por el Departamento de Microbiología de la UACJ y con base en las exigencias nutritivas de los microorganismos, S. agalatiae se sembró en Agar Infusión Cerebro y Corazón y C. albicans en Agar Papa Dextrosa (PDA). La bacteria se incubó a 37 °C por 24 h y la levadura a 28 °C durante 24 a 48 h., para transferirlas a diferentes caldos de cultivos, C. albicans se inoculó en Caldo de Soya Tripticaseína (CST) y S. agalactiae en Caldo Infusión Cerebro y Corazón (CICC), e incubarlas en las mismas condiciones previamente mencionadas. Al término de su crecimiento las cepas se ajustaron a una turbidez equivalente a 0.5 en la escala de McFarland (106 UFC/mL) en una solución de cloruro de sodio al 0.9% y a una longitud de onda de 625 nm con ayuda de un espectrofotómetro.
Evaluación antimicrobiana con el método de difusión en disco
La evaluación de la actividad antimicrobiana se llevó a cabo con el método de difusión en disco y acorde a la metodología propuesta por Kalyoncu, Oskay, Sağlam, Erdoğan & Tamer (2010) modificada. Para ello, se impregnaron discos de (6 mm de diámetro) de papel filtro (Whatman®, No. 1) con 10 µL del extracto y se dejaron secar hasta la completa evaporación del solvente. Las superficies de las placas se inocularon con 1 µL de los microorganismos, ajustados a una turbidez equivalente al 0.5 en la escala de McFarland (106 UFC/mL) con ayuda de un hisopo estéril. Los discos con el extracto de P. pistillaris se aplicaron firmemente a la superficie de la placa (4 discos por placa), pero antes se incubaron a 4 °C durante 6 h, para permitir una difusión uniforme del extracto sobre el agar. Pasado el tiempo, se volvieron a incubar a 37 °C por 24 h en el caso de S. agalactiae, y a 28 °C durante 24-48 h para C. albicans.
La actividad antimicrobiana se evaluó al medir el diámetro de la zona de inhibición. Se usaron como controles negativos los solventes de extracción y como controles positivos el antibiótico comercial eritromicina de 250 mg por ser un antibiótico que exhibe mayor actividad frente a las bacterias Gram-positivas (Lovmar et al., 2006) y el clotrimazol al 2% para la levadura, debido a que es un agente antifúngico que actúa sobre la membrana citoplasmática. Los experimentos se realizaron por duplicado. Para identificar si existían diferencias significativas en el tamaño de halo de inhibición, se realizó una prueba de t-Student entre el microorganismo y el grupo control utilizando el paquete estadístico IBM SPPS Statistic ver. 25.
Evaluación antimicrobiana mediante la concentración mínima inhibitoria
La actividad se llevó a cabo con la metodología descrita por Padilla (2012) modificada. En una primera etapa se preparó 1 mL de caldo de cultivo con el extracto respectivo. Posteriormente se agregó 1 µL de los microorganismos, previamente ajustados a una turbidez equivalente a 0.5 (106 UFC/mL) en la escala de McFarland, y se incubaron por 24 h a 37 °C para S. agalactiae y a 28 °C durante 24 a 48 h para C. albicans. Transcurrido el tiempo, se sembró 1 µL de la muestra de manera homogénea en placas con Agar Infusión Cerebro y Corazón para S. agalactiae y PDA para C. albicans. Ambas se incubaron bajo las condiciones antes mencionadas. Finalmente, se contabilizó el número de unidades formadoras de colonias (UFC) en cada placa. Para los testigos se realizaron distintas diluciones para cada microorganismo: S. agalactiae se diluyó 1:1000, donde 1 µL de los microorganismos se inocularon en 999 µL del caldo nutritivo y C. albicans se diluyó 1:100, donde 1 µL del microorganismo se inocularon en 99 µL del caldo nutritivo. Todos los experimentos se realizaron de manera independiente y por triplicado. Los resultados son la media ± el error estándar.
Se asumió que los datos seguían una distribución normal de acuerdo con lo determinado por la prueba de normalidad de Shapiro-Wilk (p>0.05). Para el porcentaje de inhibición se realizó un procedimiento de análisis probit con una gráfica de distribución de probabilidad normal, con ello se obtuvo el valor IC50 y se estimó la concentración en la que se inhibe el 50% de los microorganismos. El análisis se llevó a cabo con el programa estadístico Minitab ver. 19.
Caracterización y condiciones de cultivo in vitro
Se colocaron esporas del hongo P. pistillaris en placas con PDA para su germinación. A continuación, se incubaron a 30 °C durante cinco días para desarrollar un micelio inicial, mismo que fue resembrado hasta obtener cultivos puros (Khan, Zaidi, Khan & Pandey, 2015).
Para las pruebas de crecimiento in vitro se cortaron cubos de 0.2 mm2 del cultivo puro y se colocaron en cajas Petri de plástico de (8.1 cm de diámetro) con distintos medios de cultivo: Agar Avena (AV), Agar Maíz (AM), Agar Soya Tripticaseína (ATS), Agar Papa Dextrosa (PDA) y Agar Sabouraud (AS); en tres pH distintos: 4.8, 5.8 y 7.0. Estas se incubaron a 30 ºC y durante 10 días se midió diariamente el diámetro de crecimiento del micelio.
Por último, se evaluó el efecto del tipo medio (factor A) y el pH utilizado (factor B) sobre el crecimiento in vitro de las colonias de P. pistillaris, se usó un diseño completamente al azar y un arreglo factorial de 5x3 correspondientes a los cinco medios de cultivo y a los tres niveles de pH, con cuatro repeticiones por tratamiento. Las diferencias significativas de los factores fueron determinadas mediante un análisis de varianza ANOVA y una prueba de comparación de medias de Tukey (p≤0.05) utilizando el programa estadístico SPSS versión 25. Para el análisis estadístico se consideró como crecimiento promedio el diámetro final (mm) del inóculo fúngico menos el fragmento inicial (García, Pérez, Aldrete, Cetina-Alcalá & Vaquera-Huerta, 2006), los datos se reportan graficados con ayuda del software GraphPad Prism 8.1.2.
RESULTADOS Y DISCUSIÓN
Verificación taxonómica
Los ejemplares encontrados se caracterizan por presentar un gasterocarpo elipsoide, de coloración blanco-amarillenta, de textura leñosa-coriácea y con cutícula escamosa en general; se encuentra sostenido por un estípite cilíndrico prolongado (8.7 x 1.5 cm) a manera de columnela dentro de la gleba, este es estriado y leñoso. La gleba (8.5 x 5 cm) mostró un color blanco en estado juvenil, que se torna a café-negruzco pulverulento en estado maduro (Figura 1A), esta engloba una esporada de color marrón oscuro pulverulenta. Las esporas de (11 µm) presentan una forma globosa a subglobosa, de color café-hialina, con pared gruesa y un poro germinal (Figura 1B). Las hifas se caracterizan por su forma subcilíndrica, de pared gruesa con incrustaciones y fíbulas, hialinas a verde claro (Figura 1C).

Figura 1 Podaxis pistillaris s.l. A) Carpóforo en estado maduro; B) Esporada (100x); C) Sistema hifal (Las flechas señalan las fíbulas, 100x).
Las características morfológicas de P. pistillaris s.l. que habitan en la región desértica del norte de Chihuahua son similares morfológicamente a las de otros especímenes descritos en México (Medina-Ortiz et al., 2017), en Argentina (Wright & Albertó, 2002), en Colombia (Villalobos, Mengual & Mejía, 2017), en Estados Unidos (Bates, 2006) y otros países asiáticos (El Fallal et al., 2019).
Análisis proximal
P. pistillaris s.l. es considerado comestible y altamente valorado en diversos países, entre ellos Egipto (El-Falal et al., 2019), en India (Mridu & Atri, 2017), en Colombia (Villalobos et al., 2017), en México (Medina-Ortiz et al., 2017), en Irak (Muhsin et al., 2012), en Yemen (Al-Fatimi et al., 2006) y en Arabia Saudita (Hashem & Al-Rahmah, 1993), sin embargo, no se ha reportado su composición proximal en México.
Los resultados del análisis proximal obtenido del estudio se encuentran en el Tabla I. En general el carpóforo contiene un alto porcentaje de humedad, siendo la gleba la parte que más contiene agua. El total de carbohidratos fue detectado en un rango de 11.8 a 27.8%. En las tres muestras evaluadas, las proteínas estuvieron presentes en una mayor cantidad en el estípite (8.7%), sin embargo, en conjunto, el hongo representa un buen porcentaje de constitución proteica de un 15.2%. La fibra se detectó en un porcentaje máximo de 9.9%, siendo el estípite la parte con mayor aporte porcentual de 5.8%. Por el contrario, se observó un bajo contenido de cenizas de un 3% y de grasas de un 0.5%.
Tabla I Análisis proximal del hongo Podaxis pistillaris .
| Muestra | Kcal/100 g | H (%) | MS (%) | C (%) | P (%) | G (%) | CHO’s (%) | Na (mg) | F (%) |
|---|---|---|---|---|---|---|---|---|---|
| Gleba | 75.53 ± 0.09 | 80.10 ± 0.35 | 19.1±0.20 | 1.3 ± 0.04 | 6.5 ± 0.29 | 0.3 ± 0.00 | 11 ± 0.19 | 4.3 ± 0.09 | 4.1 ± 0.07 |
| Estípite | 104.20 ± 0.10 | 72.6 ± 0.32 | 27.4 ± 0.33 | 1.7 ± 0.02 | 8.7 ± 0.03 | 0.2 ± 0.01 | 16.8 ± 0.15 | 5.5 ± 0.12 | 5.8 ± 0.07 |
| Completo | 179.70 ± 0.23 | 76.4 ± 0.38 | 46.5 ± 0.29 | 3.0 ± 0.03 | 15.2 ± 0.32 | 0.5 ± 0.00 | 27.8 ± 0.15 | 9.8 ± 0.08 | 9.9 ± 0.06 |
H = Humedad; C = Cenizas; P = Proteínas; G = Grasas; CHO´s = Carbohidratos; Na = Sodio; F = Fibra. (MS) Media ± error estándar.
Los valores reportados en el presente estudio (Tabla I) son similares a los de Mridu & Atri (2017) en proteína de 14.54 ± 0.18; pero menores para carbohidratos de 77.79 ± 0.39, en grasa de 1.97 ± 0.16 y en fibra de 23.87 ± 2.02; y mayores para la materia seca de 15.06 ± 0.43, en humedad de 4.33 ± 0.12 y en cenizas de 1.36 ± 0.24. Otros estudios proximales del hongo realizados por Khaliel, Abou-Heilah & Kassim (1991) cuantifican valores similares de humedad del 76%, en cenizas de 2.4%, pero discrepan en la proteína de 22-37%, en carbohidratos de 18.5% y en grasas de 2.3%. Los estudios de Gupta & Singh (1991) y Jandaik & Kapoor (1976) difieren completamente en los porcentajes de proteína, estos autores cuantificaron 32.9% y 37.3%, respectivamente, en comparación con el 15.2% de proteína evaluados durante la presente investigación; estas diferencias pueden atribuirse a factores ambientales en los ecosistemas donde el hongo se desarrolla, así como la disponibilidad, calidad y accesibilidad de los nutrientes en el sustrato (Gómez-Flores et al., 2019; Moreno-Rojas, Díaz-Valverde, Arroyo, González & Capote, 2004), mismos que fueron omitidos en el presente trabajo y en la bibliografía citada, por lo que se sugiere que en estudios posteriores se aborde el efecto de estos elementos en la composición proximal y calidad nutrimental de P. pistillaris.
Es importante recalcar la falta de estudios proximales en este hongo, mismo que ha sido reconocido por su valor culinario en distintas regiones, incluyendo el centro y sur de México, donde es ampliamente consumido, cosechado o recolectado (Medina-Ortiz et al., 2017). En esta primera aproximación, la composición proximal de los carpóforos de P. pistillaris muestran un adecuado contenido en proteínas y carbohidratos, sin embargo, se requieren estudios posteriores para determinar su efecto nutricional en el consumo humano o animal. También se sugiere abordar el potencial tóxico y bioacumulativo de los metales pesados en el hongo, ya que diversos estudios han reportado a P. pistillaris como no comestible (Rasalanavho, Moodley & Jonnalagadda, 2019; Guzmán, 1977) y también se le ha asociado como tóxico en Nigeria (Alasoadura, 1966) y en Sudáfrica (Rasalanavho et al., 2019) al contener metales pesados en el tejido fúngico.
Actividad antimicrobiana
Los resultados de la evaluación antimicrobiana mediante el método en difusión de disco indican que la actividad antimicrobiana de los extractos metanólicos de P. pistillaris en C. albicans es nula, pero moderada para S. agalactiae, esto comparado con los controles positivos que tuvieron una respuesta más potente en la inhibición (Tabla II).
Tabla II Actividad antimicrobiana mediante el método de difusión en disco de Podaxis pistillaris .
| Especie | Promedio zonas de inhibición (mm) | |
|---|---|---|
| S. agalactiae | C. albicans | |
| Podaxis pistillaris | 4.0 ± 0.30b | 0.00b |
| Eritromicina | 19.375 ± 0.47a | - |
| Clotrimazol | - | 13.5 ± 0.28ª |
| Solventes | - | - |
Letras diferentes indican diferencias significativas, según la prueba de t-Student (p≤0.05). - No inhibición. Concentración del extracto 50 mg/mL. Extracto fúngico/disco: 10 µL. Solvente/disco: 10 µL. Media ± error estándar.
Los análisis por medio del método de la CMI muestran que el extracto metánolico de P. pistillartis tiene un efecto inhibitorio en ambos microorganismos valorados en una concentración mínima de 8.75 mg/mL para C. albicans y 6.25 mg/mL para S. agalactiae (Tabla III), por lo que este último es más sensible a la inhibición por influencia del extracto fúngico. A través de la gráfica probit (Figura 2) se determinó en C. albicans un IC50 = 5.63 mg/mL, mientras que para S. agalactiae un IC50 = 4.37 mg/mL.
Tabla III Unidades formadoras de colonia (UFC) por concentración del extracto metanólico de Podaxis pistillaris sobre dos microorganismos.
| Volumen extracto (µL) | Concentración (mg/mL) | UFC | |
|---|---|---|---|
| Candida albicans | Streptococcus agalactiae | ||
| 50 | 2.5 | 3225.3 ± 231.80 | 29814.33 ± 57.17 |
| 75 | 3.75 | 601.3 ± 309.10 | 15439.00 ± 10.39 |
| 100 | 5 | 8 ± 2.70 | 3103.70 ± 45.81 |
| 125 | 6.25 | 2 ± 0.99 | 0 |
| 150 | 7.5 | 2 ± 0.60 | 0 |
| 175 | 8.75 | 0 | 0 |
| Testigo | |||
| Dilución 1:100 | - | 25966.7 ± 2667.30 | - |
| Dilución 1:1000 | - | - | 581666.7 ± 33785.30 |
Media ± error estándar.

Figura 2 Gráfico probit para el porcentaje de inhibición de dos microorganismos empleando extractos metanólicos de Podaxis pistillaris s.l. A) Porcentaje de inhibición en Candida albicans (IC50 = 5.63 mg/mL). B) Porcentaje de inhibición en Staphylococcus alactiae (IC50 = 4.37 mg/mL).
Las bacterias y los hongos son considerados los microorganismos más comunes causantes de infecciones dermatológicas. Entre los patógenos bacterianos que dan lugar a diversas infecciones de la piel se encuentran Streptococcus del grupo B (Betahemolítico) (Riain, 2013). Así mismo, numerosas especies de hongos provocan una amplia gama de infecciones dermatológicas en los humanos, siendo las especies del género Candida de las más frecuentes (Suroowan & Mahomoodally, 2017). Así, los carpóforos de los hongos pueden ser empleados para propósitos terapéuticos debido a que producen una amplia variedad de componentes bioactivos en la defensa contra las bacterias, los virus e insectos (Leyva, Pérez-Carlón, González-Aguilar, Esqueda & Ayala-Zavala, 2013), al actuar como agentes antimicrobianos y alternativos al uso desmesurado de los antibióticos. Las pruebas de la actividad antimicrobiana realizadas en el presente estudio demuestran que P. pistillaris tiene una actividad moderada (halos menores a 8 mm de diámetro; Al-Fatimi et al., 2006) con el uso del método de difusión en disco, solo lograron inhibir el crecimiento de S. agalactiae de (4.0 ± 0.3 mm de diámetro) pero no el de C. albicans. Por otra parte, el método de CMI mostró inhibición en ambos microorganismos en concentraciones de 8.75 mg/mL para C. albicans y 5 mg/mL para S. agalactiae, esto coincide con otros estudios que reportan una mayor efectividad del método de dilución en caldo en comparación con el de difusión en disco al momento de evaluar la actividad antimicrobiana de los extractos fúngicos (Hleba et al., 2016; Ren et al., 2014). El método de difusión en disco como su nombre lo indica depende en gran medida de la capacidad de difusión de las sustancias presentes en los extractos (Ren et al., 2014), lo que da como resultado poca movilidad de los compuestos en el agar a causa de su baja solubilidad o alta masa molecular. La actividad antimicrobiana de P. pistillaris reportada con anterioridad por Al-Fatimi et al. (2006), identificaron que los extractos metanólicos del micelio tienen acción contra diversas bacterias gram positivas y gram negativas como: Staphyloccocus aureus, Micrococcus flavus, Bacillus subtilis, Proteus mirabilis, Serratia marcescens y Escherichia coli, con halos de inhibición que iban de los 18-30 mm. En el caso del presente estudio se realizó la evaluación a partir de los extractos del carpóforo, sin embargo, se recomienda aumentar la concentración del extracto en los discos.
Por otra parte, se ha indicado que los extractos etanólicos del carpóforo tienen un efecto inhibitorio sobre el crecimiento de las bacterias fitopatógenas como Xanthomas axonopodis pv. Punicae, B. pumilis y Pseudomonas siringe, y los hongos fitopatógenos como Aspergillus niger, A. solanium, Alternaria solani, Colletotrichum graminicola, Fusarium oxysporum, F. solani y Helminthosporium maydis en CMI que van desde 2-18 mg/mL (Feleke & Doshi, 2017), valores que están dentro del rango realizado en el presente estudio para las bacterias patógenas en los humanos. Sin embargo, al comparar el método de difusión en disco se pueden apreciar halos de inhibición superiores, ya que estos autores citan medidas de 9-29 mm y de 15-45 mm para las bacterias y hongos fitopatógenos, respectivamente. Esto puede atribuirse a las diferencias en el hábito alimenticio, en la pared celular de los microorganismos y a la propia resistencia que genera la cepa frente a los antibióticos (Walsh & Amyes, 2004). La pared celular fúngica puede ser la razón por la relativa alta resistencia de C. albicans frente a los agentes antimicrobianos (Feleke & Doshi, 2017). Se recomienda realizar posteriores estudios empleando otras especies bacterianas y fúngicas de carácter patógeno, así como realizar extractos de P. pistillaris con distintos solventes al metanol (p. ej. etanol, acetato de etilo, acetona) para evaluar la eficacia de estos.
Caracterización y crecimiento in vitro
En el Tabla IV se describe la morfología de las colonias que presentó P. pistillaris en los diferentes tratamientos. En general se observaron colonias circulares con márgenes y superficies irregulares, consistencia algodonosa y en ocasiones con presencia de hifas aéreas; la coloración varió de acuerdo con el medio de cultivo, con un micelio blanco, hasta amarillento y marrón oscuro (Figura 3).
Tabla IV Comparación de la morfología colonial de Podaxis pistillaris obtenida diez días después de la siembra en cinco medios nutritivos y tres pH diferentes.
| Medio nutritivo | pH | Forma | Margen | Elevación | Superficie | Consistencia | Color anverso | Color reverso | Transmisión de luz |
|---|---|---|---|---|---|---|---|---|---|
| PDA | 4.8 | Circular | Irregular | Media | Concéntrica | Algodonosa | Blanco | Blanco ligeramente amarillento | Opaco |
| 5.8 | Circular | Irregular | Media | Concéntrica | Algodonosa | Blanco | Blanco ligeramente amarillento | Opaco | |
| 7.0 | Circular | Irregular | Media | Concéntrica | Algodonosa | Blanco | Marrón-cobrizo | Opaco | |
| ATS | 4.8 | Circular | Irregular | Sin elevación | Irregular | Algodonosa | Blanco | Marrón oscuro | Opaco |
| 5.8 | Circular | Irregular | Sin elevación | Irregular | Algodonosa | Blanco | Amarillo | Opaco | |
| 7.0 | Circular | Irregular | elevación | Irregular | Algodonosa | Amarillo | Amarillo | Opaco | |
| AS | 4.8 | NC | NC | NC | NC | NC | NC | NC | NC |
| 5.8 | Circular | Liso a filamentoso | Media | Concéntrica | Algodonosa | Blanco | Marrón y amarillo | Opaco | |
| 7.0 | Circular | Irregular filamentoso | Media | Irregular | Algodonosa | Blanco | Amarillo | Opaco | |
| AV | 4.8 | Circular | irregular filamentoso | Elevada plana | Irregular | Algodonosa | Blanco | Blanco ligeramente amarillento | Opaco |
| 5.8 | Circular | irregular filamentoso | Elevada plana | Irregular | Algodonosa | Blanco | Blanco ligeramente amarillento | Opaco | |
| 7.0 | Circular | irregular filamentoso | Elevada plana | Irregular | Algodonosa | Blanco-gris | Blanco con áreas marrón | Opaco | |
| AM | 4.8 | Circular | irregular filamentoso | Elevada | Irregular | Algodonosa | Blanco y marrón | Marrón oscuro | Opaco |
| 5.8 | Circular | irregular filamentoso | Elevada | Irregular | Algodonosa | Blanco y marrón | Marrón oscuro | Opaco | |
| 7.0 | Circular | irregular filamentoso | Elevada | Irregular | Algodonosa | Blanco y marrón | Marrón cobrizo | Opaco |
PDA: Agar Papa Dextrosa, ATS: Agar Tripticasa soya, AS: Agar Sabouraud, AV: Agar Avena AM: Agar Maíz. NC= No crecimiento. Temperatura: 30 °C.
Figura 3 Morfología colonial de Podaxis pistillaris a los diez días de incubación (30 °C). A) Anverso pH de 4.8; a) Reverso pH de 4.8; B) Anverso pH de 5.8; b) Reverso pH de 5.8; C) Anverso pH de 7.0; c) Reverso pH de 7.0. AM: Agar Maíz, AV: Agar Avena, PDA: Agar Papa Dextrosa, AS: Agar Sabouraud, ATS: Agar Tripticasa Soya.
El diámetro de las colonias en cada uno de los tratamientos se midió diario hasta que alcanzaron la totalidad de la caja Petri. El diámetro de las colonias obtenido al décimo día se muestra en la Figura 4. Se logra observar que el crecimiento máximo es de 8.1 cm y con mayor eficiencia se obtuvo en el medio de cultivo AM (p≤0.05); también, se detectaron diferencias significativas entre el pH (p≤0.05), ya que los valores de 7.0 y 5.8 son los que mayor efecto tuvieron en el desarrollo y crecimiento del hongo. Lo anterior es acorde con las características ecológicas del hongo, ya que suele crecer en suelos poco desarrollados (litosoles o regosoles) con un pH que va de 6.0 a 8.0 (Esqueda et al., 2012), por ello, se sugiere cultivarlo en medios de Agar Maíz con un pH de 7.0 para asegurar su máximo rendimiento. El medio en el que se obtuvieron los rendimientos más bajos fue en ATS de (1.5-2.0 cm después de diez días), así como en el medio AS con un pH de 4.8 en el que no hubo respuesta de crecimiento.

Figura 4 Crecimiento in vitro de Podaxis pistillaris en cinco medios de cultivo y tres pH distintos. PDA: Agar Papa Dextrosa, ATS: Agar Tripticasa Soya, AS: Agar Sabouraud, AV: Agar Avena AM: Agar Maíz. Temperatura: 30° C. Medidas registradas a 10 días de crecimiento. Media ± error estándar.
En el Tabla IV se describe la morfología de las colonias que presentó P. pistillaris en los distintos tratamientos (medio de cultivo y pH). En general se observó que no existen grandes diferencias en la morfología cuando se utiliza un pH diferente en el mismo medio de crecimiento, sin embargo, sí existen entre un medio y otro (Figura 3). El micelio desarrollado por P. pistillaris varía ligeramente entre tratamientos en la forma del margen, la elevación y el color del reverso de la colonia, estas diferencias se observan más al utilizar AM y AV (Tabla IV). Estas pueden explicarse por el tiempo de crecimiento del micelio, ya que aquellos que se desarrollaron en AM sin importar el pH alcanzaron el diámetro máximo de crecimiento de 8.1 cm a los cinco días de incubación, estos resultados son similares a los obtenidos por Nieto, Amora & Guerra (2012) y García et al. (2006), quienes observaron desarrollo en la elevación del micelio e intensidad en su pigmentación y medio de cultivo al transcurrir el tiempo. Así mismo, es importante considerar que existe un número considerable de polimorfismos tanto en los carpóforos, las esporas y las cepas de P. pistillaris (Medina-Ortiz et al., 2017) según el lugar en que se encuentren y de la formulación de los medios de cultivo empleados (Megumi et al., 2010; Kasuya, Coelho, Tamai, Miyamoto & Yajima, 2008).
Los resultados del crecimiento de P. pistillaris en los distintos medios se pueden resumir en el siguiente orden: AM >AV>PDA>AS>ATS. Estos contrastan a los reportados por Khan et al. (2015), quienes también evaluaron la eficiencia del crecimiento de P. pistillaris en siete diferentes medios de cultivo líquidos, siendo el AM el penúltimo en eficiencia, sin embargo, en ambos estudios se concluye que el medio AS es el que presenta menor crecimiento y desarrollo micelial. Los resultados muestran que el mejor desempeño se obtuvo en los medios a base de maíz y de avena, al respecto Lin & Chen (2007) mencionan que los medios elaborados con harinas disponen de una relación de carbono y nitrógeno ideal para la producción de la biomasa y otros metabolitos.
De acuerdo con el análisis estadístico, se obtuvo mejor crecimiento en un pH de 7.0 y 5.8 (p≤0.05). Lo anterior concuerda con Khan et al. (2015), quienes encontraron que el mejor pH para estimular el crecimiento del micelio de P. pistillaris fue de 6.5, con un desarrollo similar en un medio a pH 5.5, mientras que los valores más bajos se encontraron en medios más ácidos (4.0-4.6). Esto podría explicar el por qué no existió desarrollo micelial en el tratamiento de AS a un pH de 4.8. La importancia de realizar este tipo de pruebas radica en la estandarización de los parámetros óptimos de nutrición y temperatura para el crecimiento in vitro, mismos que permitirán la obtención de una biomasa fúngica eficiente y en menor tiempo.
Finalmente, en Vázquez-García, Santiago-Martínez & Estrada-Torres, (2002)Terfeiza albiensis creció bien de un pH neutro a uno alcalino de (7.0-8.0); esto por ser una especie que se desarrolla en sustratos calcáreos y secos; si bien estos rangos están dentro de los que se obtuvieron en el presente estudio para P. pistillaris, los autores anteriormente mencionados sugieren emplear pH que simulen las condiciones en las que crecen los hongos en el campo. Esto lo corroboran nuevamente Sharma, Singh, Kumar, Kamal & Singh (2015) en cultivos in vitro de hongos desertícolas del género Phellorinia, con resultados que indican que el hongo requiere de una alta temperatura de (40 °C) y un pH levemente alcalino de 7.5, que normalmente se encuentra en los desiertos de Rajasthan (India). Al considerar que P. pistillaris se desarrolla en suelos arenosos y ricos en sales (alcalinos), se recomienda utilizar un pH de 7.0 para obtener un mejor desarrollo del micelio, y a su vez, es necesario realizar más estudios para establecer cómo se comportaría a un pH de 7.5 y 8.0, así como evaluar el efecto del incremento en la temperatura.
Conclusiones
Los resultados obtenidos del estudio proximal revelaron que P. pistillaris es una especie rica en proteínas (15.2%) y en carbohidratos (27.8%) y con un bajo contenido en grasas (0.5%). Estos hongos también tienen una importante composición porcentual en fibra del (9.9%).
Se demostró una actividad antimicrobiana moderada al emplear el método de difusión de disco con extractos metanólicos y solamente frente a S. agalactiae (halo de inhibición de 4.00 mm), no hubo inhibición en C. albicans con este método. Por otra parte, la CMI de los extractos metanólicos de P. pistillaris se logró a una concentración de 8.75 mg/mL para C. albicans y de 6.25 mg/mL para S. agalactiae.
El crecimiento micelial de P. pistillaris fue mayor en los medios de cultivo a base de harinas, principalmente con Agar Maíz al desarrollar un diámetro máximo de 8.1 cm a los cinco días de inoculado. El Agar Avena también mostró resultados similares. Se presentó un buen crecimiento con un pH de 7.0 y 5.8. Por las características ecológicas del hongo, se recomienda el crecimiento in vitro en medios de cultivo con base en Agar de Maíz y un pH de 7.0.











 nueva página del texto (beta)
nueva página del texto (beta)


